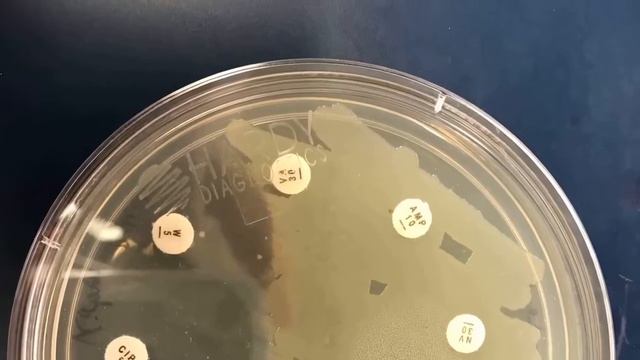
Small World Initiative Movie Trailer смотреть онлайн

Автор: Тайная игра на столе Страница 10

сегодня на втором уроке химии рассказывали нам про...

Third Age Total war (DaC 1.2) - Изенгард #17 Древобород? Опять?

TBR czyli plany czytelnicze na CZERWIEC

Большая Игра в МЛМ "Прорыв Чемпионов" | День 13 | Мастер класс

How to build: 014 Curly made Unicorn EUGY

Nemezida Club | Meetup | Agile, CI/CD, AzureDevOps
Small World Initiative Movie Trailer

8 Марта в офисе для компании "ТехноНИКОЛЬ"

HMKids - Ultramarines (Video)

Игра бом бич

Gobbo & Janet Podcast #2 .feat Ondjage | Empire Build Guide | Total War: Warhammer II

Kena Bridge of Spirits #07 PS5 / Rusus Haus wir befreit. es ist heftig, so viele versuche 😮

Delivered via Normal Spontaneous Delivery/Normal Birth Vlog

The Toilet Paper Frenzy of 2020

Гомер язы.(cover)

💥Como ser GLORIA MITICA SIEMPRE Micro-Game y Macro-Game #1

ПРОХОЖДЕНИЯ ИГРЫ ЗАМОК ВОЛЬФЕНШТЕЙН 3 ЧАСТЬ!

Urban Trial Freestyle gameplay

Stellaris 2.6.3 - Overview - Federation Types

игра если что не говорит я пишу и озвучка не моя.

Beasts of Bermuda- Таинственный лес

The Panda Nursery | LEGO Minecraft

"Лайфхаки для Бизнес-Леди" настольная книга.

Распаковка и обзор игрушки Дарта Вейдера с Ваней
За каждым успешным каналом стоит личность, идея и сотни часов кропотливого труда. Если вы здесь, значит, автор «Тайная игра на столе» уже сумел зацепить ваше внимание своим уникальным стилем или подачей. А мы на RUVIDEO позаботились о том, чтобы вы могли изучить весь архив его работ в максимально комфортных условиях — без лишней суеты и преград.
Почему за работами канала «Тайная игра на столе» так интересно наблюдать? Всё просто: это честный контент, который находит отклик в сердцах зрителей. На нашем ресурсе вы можете смотреть онлайн все видео любимого автора бесплатно и в хорошем качестве. Нам важно, чтобы вы видели каждую деталь и слышали каждый нюанс, поэтому мы используем только стабильные плееры из открытых источников Rutube.
Следите за новинками канала, пересматривайте старые шедевры и открывайте для себя новые грани творчества «Тайная игра на столе». Мы постоянно обновляем ленту, чтобы у вас под рукой всегда были самые свежие выпуски. Никаких сложных регистраций — только вы и творчество, которое вдохновляет. Приятного вам путешествия по миру авторского контента на RUVIDEO!
Видео взято из открытых источников Rutube. Если вы правообладатель, обратитесь к первоисточнику.